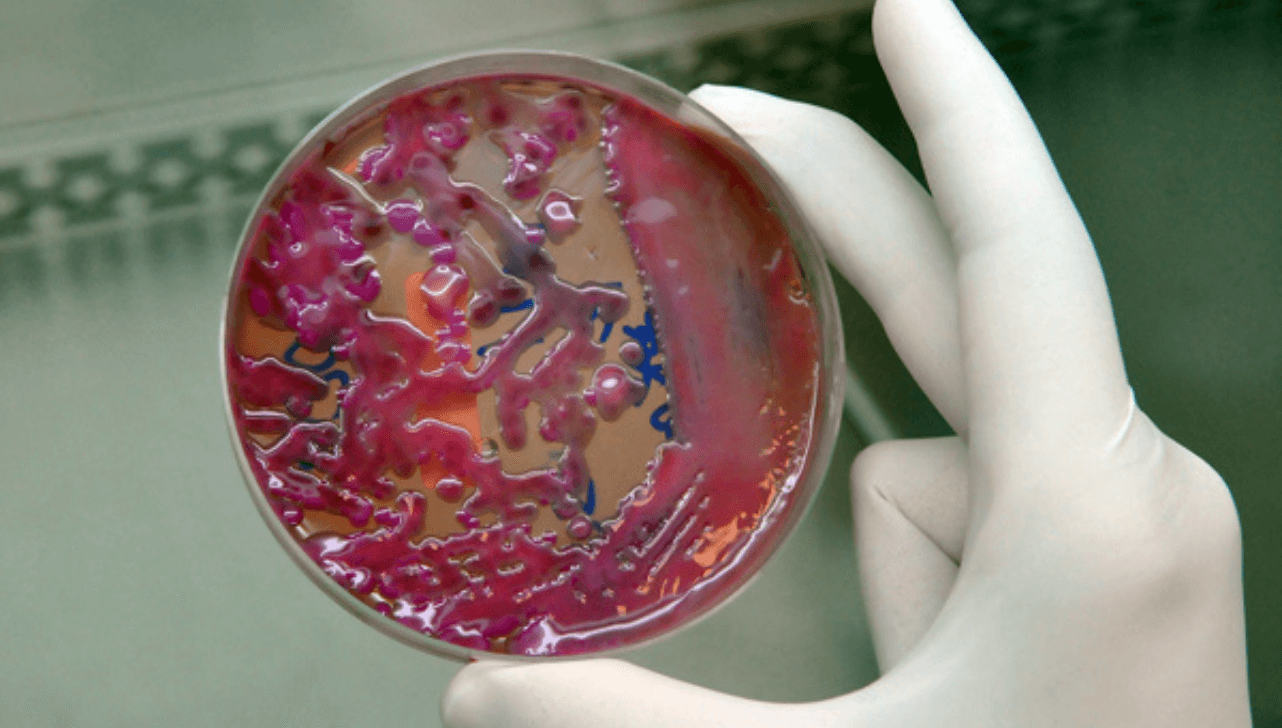

A descoberta de sete pacientes infectados com a superbactéria KPC (Klebsiella pneumoniae carbapenemase) levou o Hospital Municipal Dr. Mário Gatti, em Campinas (SP), a fechar temporariamente a UTI Adulto a partir desta terça-feira (10). A medida foi tomada para conter o avanço do microrganismo multirresistente, que é resistente aos antibióticos de amplo espectro e pode agravar quadros de saúde, levando a infecções generalizadas muitas vezes fatais.
Segundo a administração do hospital, mesmo após a higienização completa dos leitos, que inclui camas e até paredes, a bactéria continuou presente na unidade. Para evitar novas infecções, a entrada de pacientes na UTI foi suspensa temporariamente.
Novos casos que necessitarem de tratamento intensivo serão transferidos para o Hospital Ouro Verde ou para outras unidades da região, com o apoio do Serviço de Atendimento Móvel de Urgência (Samu), que já foi orientado a não encaminhar pacientes para o Mário Gatti.
Os sete pacientes contaminados serão mantidos isolados em um salão da UTI, enquanto outros três que já estavam na ala serão transferidos para outros leitos, conforme informou a Prefeitura de Campinas.
A KPC é uma bactéria multirresistente que produz uma enzima capaz de inativar a ação de antibióticos de amplo espectro, como os carbapenêmicos, tornando o tratamento das infecções extremamente difícil. O microrganismo é transmitido por secreções de pacientes infectados, especialmente quando falham os serviços de higiene e desinfecção hospitalar.
Crianças, idosos, pessoas debilitadas, portadores de doenças crônicas e aqueles submetidos a longos períodos de internação hospitalar correm maior risco de contrair a bactéria. A KPC pode causar pneumonia e infecções sanguíneas, que podem evoluir para um quadro de infecção generalizada (sepse), muitas vezes fatal.
O hospital afirmou que outras medidas já vinham sendo adotadas, como limpezas terminais de leito, intensificação da higienização das mãos e treinamentos para as equipes. Em nota, a Prefeitura de Campinas reforçou o compromisso com a segurança dos pacientes e a transparência nas informações.
“A Rede Municipal Dr. Mário Gatti reafirma seu compromisso com a segurança dos pacientes, a qualidade da assistência e a transparência nas informações prestadas à população”, acrescentou a administração.